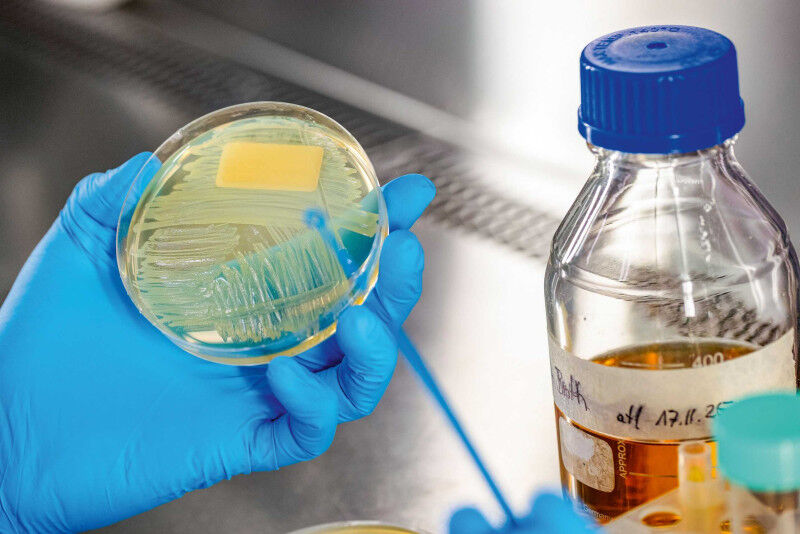

Questo testo è apparso nel numero 26/01 della rivista Globe dell’ETH
Peter Wick dirige un laboratorio in cui tutto ruota intorno a materiali costituiti da particelle piccolissime, di dimensioni nanometriche. Nel suo laboratorio, gli scienziati studiano come questi materiali interagiscono con il corpo umano, quali rischi per la salute comportano e quali opportunità offrono per risolvere i problemi di salute
Wick e il suo laboratorio si dedicano a queste domande da oltre vent’anni. Come docente e, dal 2023, professore aggiunto presso il Dipartimento di Scienze e Tecnologie della Salute, è strettamente legato al Politecnico di Zurigo. Un argomento che gli sta particolarmente a cuore è la crescente resistenza agli antibiotici: "Abbiamo urgentemente bisogno di nuovi approcci per prevenire e trattare le infezioni. Perché sempre più agenti patogeni non possono più essere combattuti con gli antibiotici esistenti"
Il suo laboratorio - nell’ambito della ricerca dell’Empa sulla salute - sta quindi sviluppando nanomateriali che hanno un effetto antimicrobico, cioè uccidono batteri e virus. In futuro, questi materiali potrebbero essere utilizzati per rivestire i cateteri, ad esempio, per prevenire la colonizzazione microbica. Oppure le medicazioni dotate di un nanostrato di questo tipo potrebbero favorire la guarigione delle ferite prevenendo le infezioni
Strato sottilissimo
I nanomateriali con proprietà antimicrobiche sono già utilizzati in medicina, ad esempio a base di argento, rame o biossido di titanio. Tuttavia, queste soluzioni contenenti metalli presentano anche degli svantaggi. Alcune possono scatenare allergie, ad esempio. Altre funzionano bene contro i batteri, ma difficilmente contro i virus. Il laboratorio "Nanomateriali per la salute" sta quindi ricercando nuovi materiali che superino questi svantaggi. Grazie ai finanziamenti dell’UE, nel 2023 Wick ha potuto assumere il chimico Giacomo Reina come responsabile del progetto. Egli si è subito messo alla ricerca di elementi costitutivi adatti per questi nanomateriali antimicrobiciLa prima importante ispirazione gli è venuta da un partner di ricerca della Repubblica Ceca. Un team dell’Università ceca Palacký di Olomouc aveva sviluppato un materiale basato sul grafene, una forma di carbonio costituita da un solo strato di atomi. Reina ha immediatamente riconosciuto il potenziale del materiale, anche per la medicina. È iniziata una ricerca approfondita per scoprire come il materiale potesse essere ulteriormente sviluppato per soddisfare le esigenze della lotta contro i microbi. "Abbiamo bisogno di nanomateriali che siano antimicrobici, ma anche biocompatibili, ecologici e stabili", afferma Reina
La prima versione di un materiale adatto si presenta così: Il grafene è incorporato sotto forma di acido grafenico in una plastica utilizzata anche nell’industria alimentare: l’alcol polivinilico. Reina solleva una piccola lastra di vetro su cui apparentemente non si vede nulla: "Il nostro nanomateriale è uno strato sottilissimo e trasparente. Questo ha il vantaggio di poter essere applicato in modo invisibile su vari prodotti"

Reina ha già sintetizzato quattro diversi materiali, cercando sempre di migliorare ulteriormente le proprietà desiderate, come spiega in laboratorio: "A nostra conoscenza, questi sono i primi rivestimenti antimicrobici a base di acido grafenico"
Attraverso la pelle nel tessuto
I nanomateriali sono caratterizzati da un’altra particolarità: Le loro proprietà antimicrobiche possono essere attivate solo con la luce. Il laboratorio di Wick ha già sviluppato nanomateriali e sostanze che sono di per sé antibatteriche, anche senza l’aggiunta della luce. Questo può essere utilizzato, ad esempio, per le tende degli ospedali. Per altre applicazioni, tuttavia, è un vantaggio dover attivare il rivestimento con la luce. "Questo permette di attivare e disattivare l’effetto in modo mirato e di dosare con precisione una quantità maggiore o minore di energia luminosa", spiega ReinaCome fonte di luce adatta, i ricercatori di San Gallo si sono imbattuti nelle lampade a infrarossi, già utilizzate negli ospedali per la terapia del dolore. In laboratorio, Reina e la dottoranda Paula Bürgisser si preparano per un esperimento e indossano gli occhiali protettivi: Questa volta, il nanomateriale viene riempito in piccoli vasi e riscaldato a circa 44 gradi Celsius dal fascio di luce giallo-arancione
In questo modo, i batteri e i virus vengono uccisi in due modi: Da un lato, i microbi vengono indeboliti dall’aumento della temperatura. Ma soprattutto, la luce innesca una reazione chimica tra il nanomateriale e l’ossigeno presente nell’aria. Questo produce i cosiddetti radicali dell’ossigeno. Questi danneggiano la superficie dei batteri, causandone la morte o, nel migliore dei casi, l’inattivazione
La luce infrarossa ha un altro vantaggio: può penetrare fino a circa due centimetri nei tessuti. Questo permette, ad esempio, di attivare dall’esterno un impianto rivestito sotto la pelle
Wick osserva i suoi ricercatori e si meraviglia della bellezza del processo: "Non è fantastico? Usiamo l’energia fisica per innescare un processo chimico che ha effetti biologici"
Germi ospedalieri illuminati
Il fatto che l’idea funzioni davvero si può vedere un piano più in alto, nello stesso edificio dell’Empa. Qui si trova il "Lab for Biointerfaces", dove i nuovi materiali vengono messi alla prova in un laboratorio di biosicurezza: Hanno davvero un effetto antimicrobico? Il test viene effettuato utilizzando due germi ospedalieri pericolosi e spesso resistenti e un virus. I test con il primo dei quattro materiali hanno avuto successo: quasi il 100% dei germi è stato ucciso per un tipo di batterio e circa il 91% per l’altro. L’efficacia è stata quindi significativamente migliore di quella dei rivestimenti d’argento esistenti, ad esempioIn un’altra stanza del laboratorio, le cellule cutanee coltivate possono essere utilizzate per verificare se i nanomateriali hanno effetti collaterali, cosa che non si è ancora verificata. Inoltre, non ci sono segni di resistenza nei microbi. E i 44 gradi Celsius - più di una febbre alta: le proteine del nostro corpo non iniziano a dissolversi? Wick è rassicurante: il trattamento è così localizzato che al massimo viene danneggiato pochissimo tessuto, che si rigenera di nuovo
Impianti dentali sicuri
La cosiddetta fase di "proof of concept" è stata completata: Il team è riuscito a dimostrare con le analisi che l’idea funziona. Tuttavia, Wick afferma: "Siamo solo all’inizio del nostro viaggio" Il compito ora è quello di continuare a testare diverse composizioni chimiche del materiale e tipi di illuminazione, al fine di ottimizzare l’efficacia antimicrobica per applicazioni specifiche. Un’opzione potrebbe essere quella di utilizzare il laser al posto delle lampade a infrarossi, con il vantaggio di poter attivare il nanomateriale in modo ancora più specifico. Si attende anche la prova dell’acido: il principio funziona anche nel corpo umano, dove i microbi spesso si accumulano in biofilm e sono quindi più protetti, ad esempio dagli antibiotici?I ricercatori hanno scelto l’odontoiatria come prima applicazione medica specifica, con il sostegno finanziario di due fondazioni. Gli impianti dentali possono causare gravi infezioni che possono diffondersi all’osso mascellare o addirittura a tutto il corpo. Dall’estate del 2025, il progetto di tesi di Bürgisser si concentra su come prevenire questo fenomeno con l’aiuto di nanomateriali
Durante gli studi in Scienze e tecnologie della salute all’ETH, l’ex borsista di eccellenza stava già lavorando alla sua tesi di Master nel laboratorio di Wick. Nell’ambito del dottorato, ora lavora con Ronald Jung del Centro di medicina dentale dell’Università di Zurigo. Farà la pendolare: Sviluppare nanomateriali a San Gallo, effettuare analisi antimicrobiche a Zurigo
Materiale instancabile
L’idea: quando un paziente riceve un impianto dentale, in futuro la parte superiore dell’impianto potrebbe essere rivestita di nanomateriale. Dopo l’inserimento, questo viene illuminato brevemente per uccidere eventuali microbi presenti. Il processo potrebbe essere ripetuto durante i regolari controlli dentistici. Se si sviluppa un’infezione, l’impianto potrebbe essere illuminato di nuovo. Test precedenti hanno dimostrato che "il materiale non si affatica, può essere illuminato più volte e ha un effetto antimicrobico", dice ReinaSe tutto va bene, il team spera di essere pronto tra tre o quattro anni a cercare un partner industriale per la fase successiva di sviluppo: la sperimentazione clinica. Probabilmente ci vorranno altri dieci o quindici anni prima che l’applicazione raggiunga i pazienti, stima Wick
Il team ha già in mente altre applicazioni mediche. Per Wick è chiaro: "I nanomateriali possono dare un contributo significativo alla medicina. Siamo solo all’inizio, perché la ricerca di base fornisce costantemente nuovi spunti" Oltre alla lotta contro i virus e i batteri resistenti, Wick pensa anche alla costruzione di sensori altamente sensibili o all’uso di nanomateriali per trattare malattie come il cancro. In questo modo, alla periferia di San Gallo nascono innovazioni che un giorno potrebbero fare il giro del mondo





